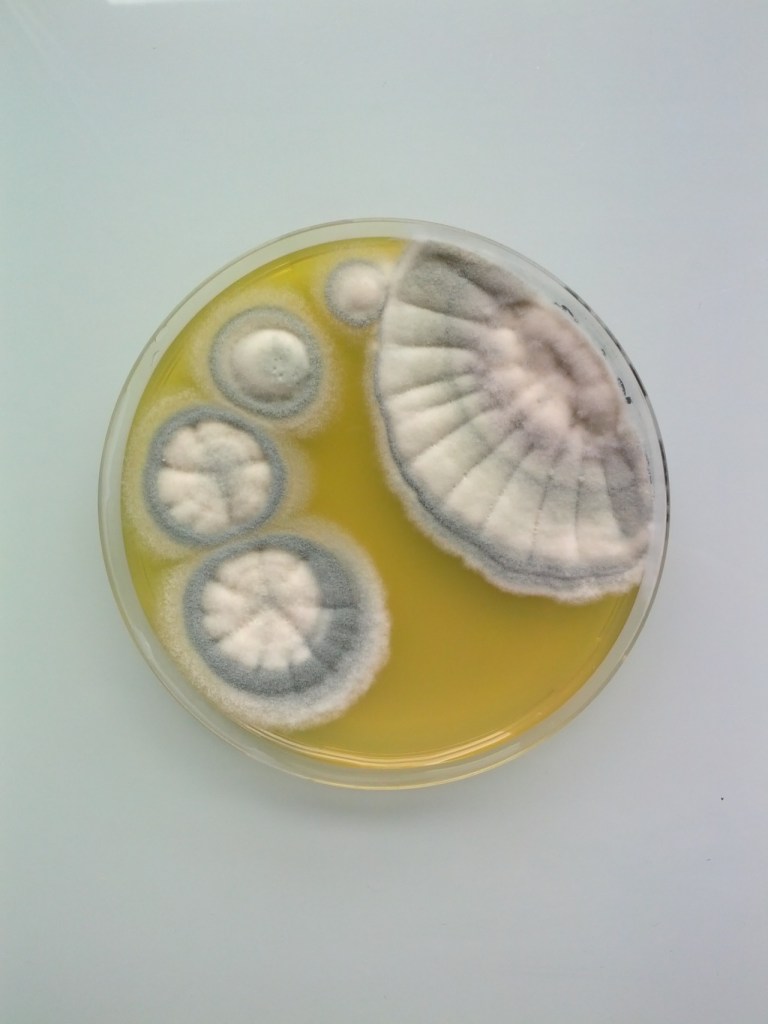
mw9h7zENTm1rfxttzo1_1280
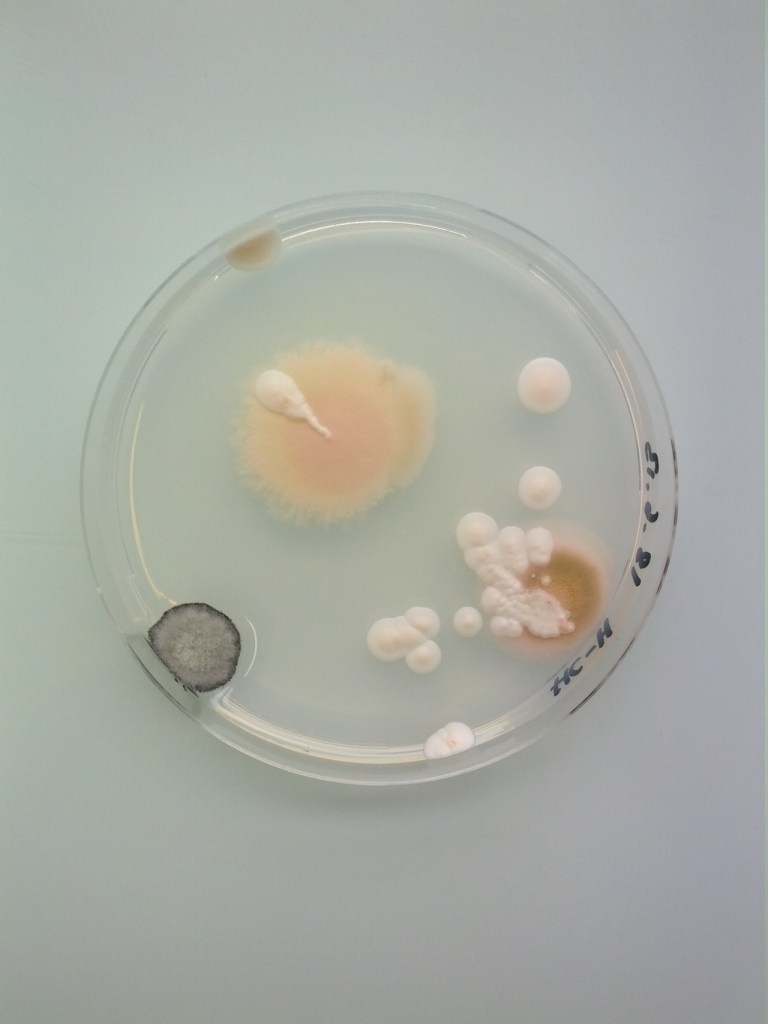
mxe78wuTP41rfxttzo1_1280
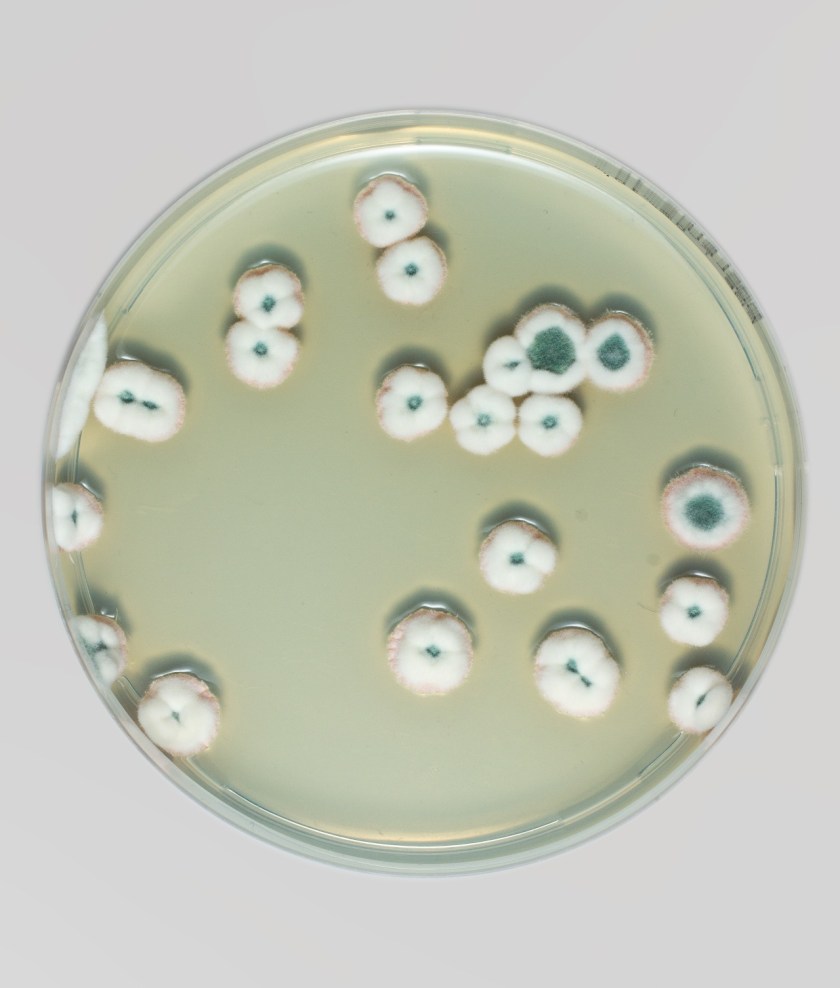
tumblr_nfi5fxshnP1rfxttzo1_1280

It’s been a while since we’ve discovered these weird creations, but every time is like the first and we found ourselves kind of hypnotized by it. Yes, it is exactly what you’re thinking, moulds and fungi in Petri dishes by Antoine Bridier-Nahmias. Do you think mould can turn into art?
// E’ da un po’ di tempo che abbiamo scoperto queste strane creazioni ma ogni volta è come la prima e rimaniamo ipnotizzate ad osservarle. Sì, è proprio quello che pensate, muffe e funghi in piastre di Petri ad opera di Antoine Bridier-Nahmias. Pensate che la muffa possa trasformarsi in arte?
All pictures © Magical Contamination. (See all the collection on the tumblr)